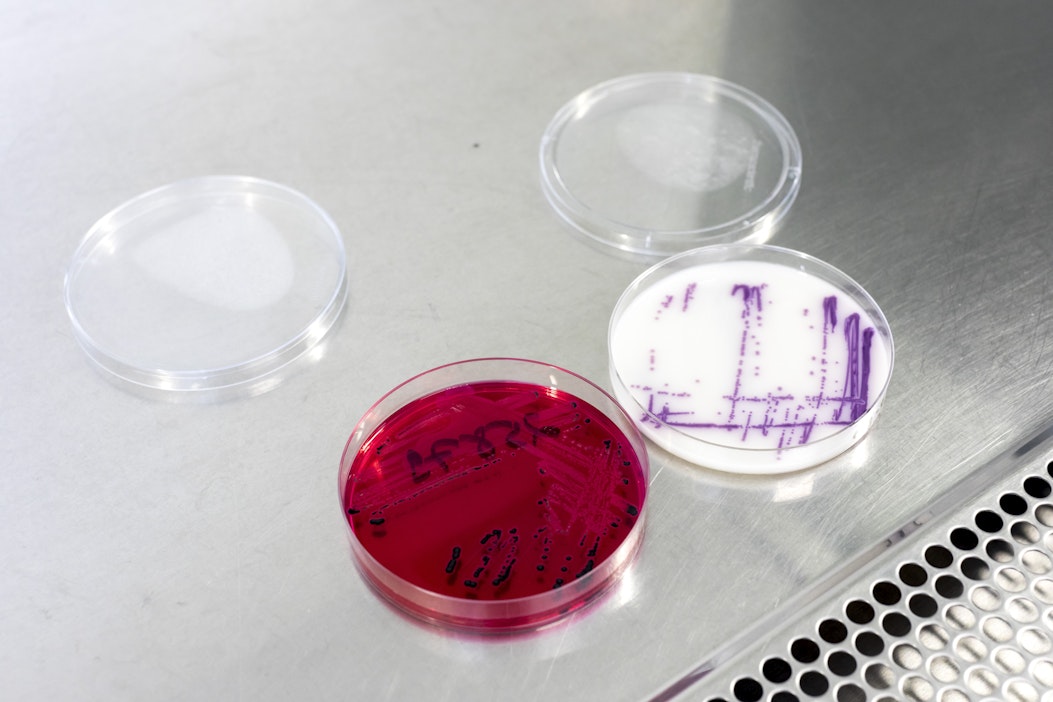
Salmonellapesäkkeitä testausalustoilla.

Salmonellavahingon kattava tuotevastuuvakuutus lisätään ETT:n positiivilistan ehtoihin
Yrityksille on annettu toukokuun 2023 loppuun saakka aikaa sitoutua uusittuihin sääntöihin.Eläinten terveys ETT ry ylläpitää rehualan toimijoista niin sanottua positiivilistaa. Sille pääsee, kun yrityksen riskienhallinta taudinaiheuttajien suhteen täyttää tietyt tiukat kriteerit.
Listalle pääsyn edellytyksenä on muun muassa se, että jokaiselle maahan tuodulle rehuerälle tehdään salmonellakontrolli.
Nyt positiivilistan ehtoihin on kirjattiin vaatimus tuotevastuuvakuutuksesta, joka kattaa salmonellan aiheuttamat vahingot. Vakuutuksen kattavuus pitää mitoittaa asiakaskunnan rakenteen ja mahdollisten vahinkojen suuruuden mukaan.
Yrityksille on annettu toukokuun 2023 loppuun saakka aikaa sitoutua uusittuihin sääntöihin.
Artikkelin aiheet- Osaston luetuimmat